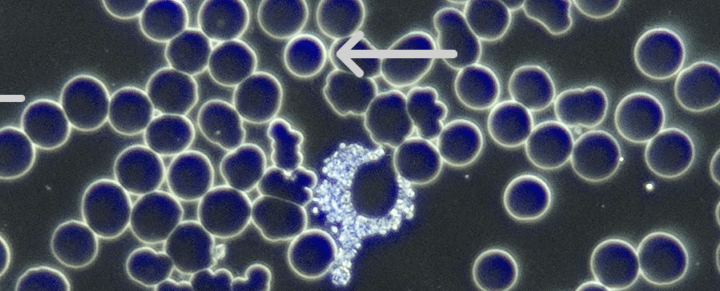

Neutrophils: Non Viable
Appearance Non-viable neutrophils are: A healthy neutrophil is irregular, dynamic, and actively streaming — the opposite of the non-viable pattern. Meaning & Implications Non-viable neutrophils are one of the strongest indicators of immune suppression, linked…

Disclaimer
Disclaimer